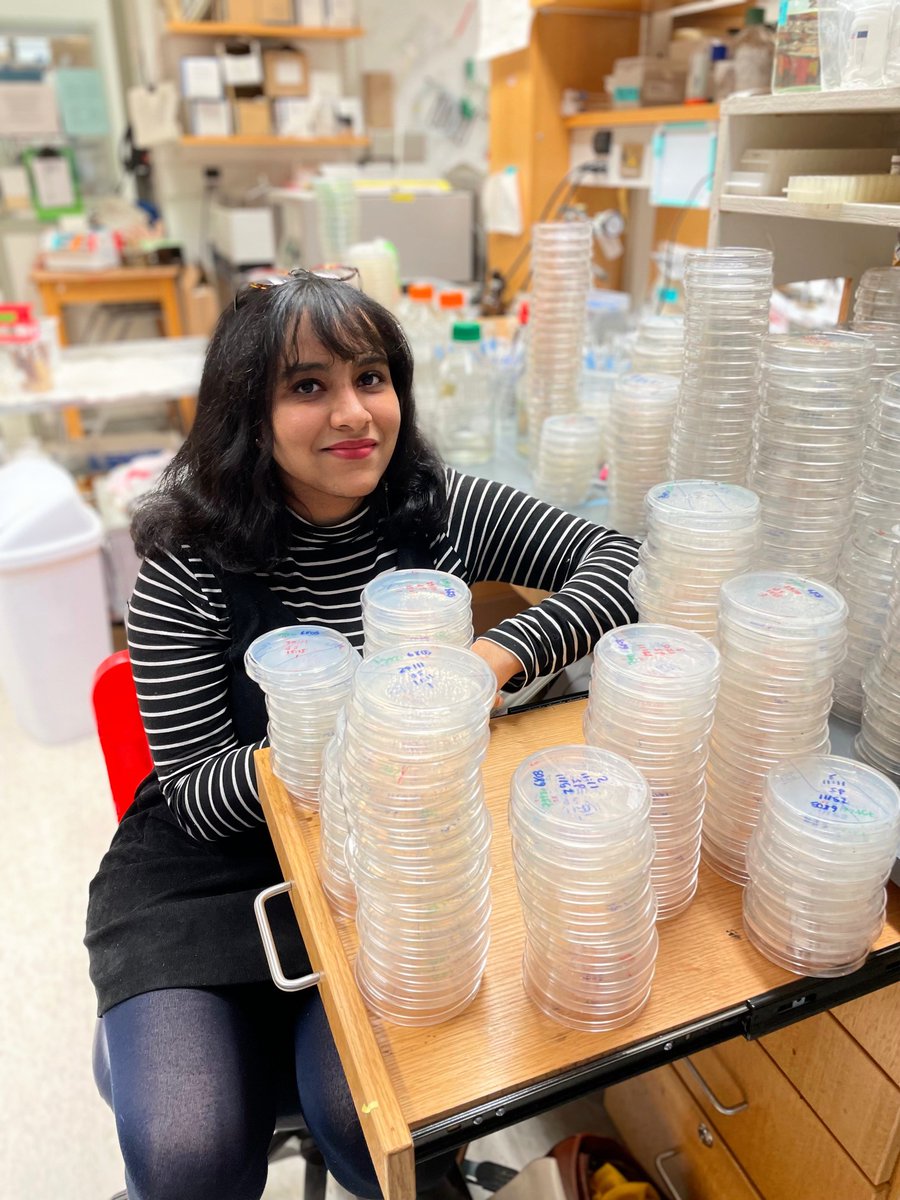
EvolutionVU tweet media

Benjamin Bratton
266 posts

Benjamin Bratton
@bpbratton
Christian, husband, father, biophysicist, views my own (he/his/him) Assistant Professor at VUMC Pathology, Microbiology and Immunology







🚨This week in @PNASNews 🚨 Our new paper led by @sb_worthan examining a pH sensitive substitution in the Rho transcription terminator that evolved experimentally in the lab and then found in natural populations! pnas.org/doi/10.1073/pn… A thread 🧵!



New Research Alert! Cyanobacteria, tiny but mighty, can anticipate the seasons by sensing changes in day length! @M_louisae with the great publication in @ScienceMagazine #evolution

5/ How do microbial🦠 communities communicate between single cells to behave like multicellular organisms? Awardee @C__Ellison hypothesizes that bacterial cell components (such as pili) are critical modulators. 🎉 Congrats Dr. Ellison! @universityofga 🙏#HFScout @BhayaDevaki




Evolution of pH-sensitive transcription termination during adaptation to repeated long-term starvation. biorxiv.org/cgi/content/sh… #biorxiv_micrbio









